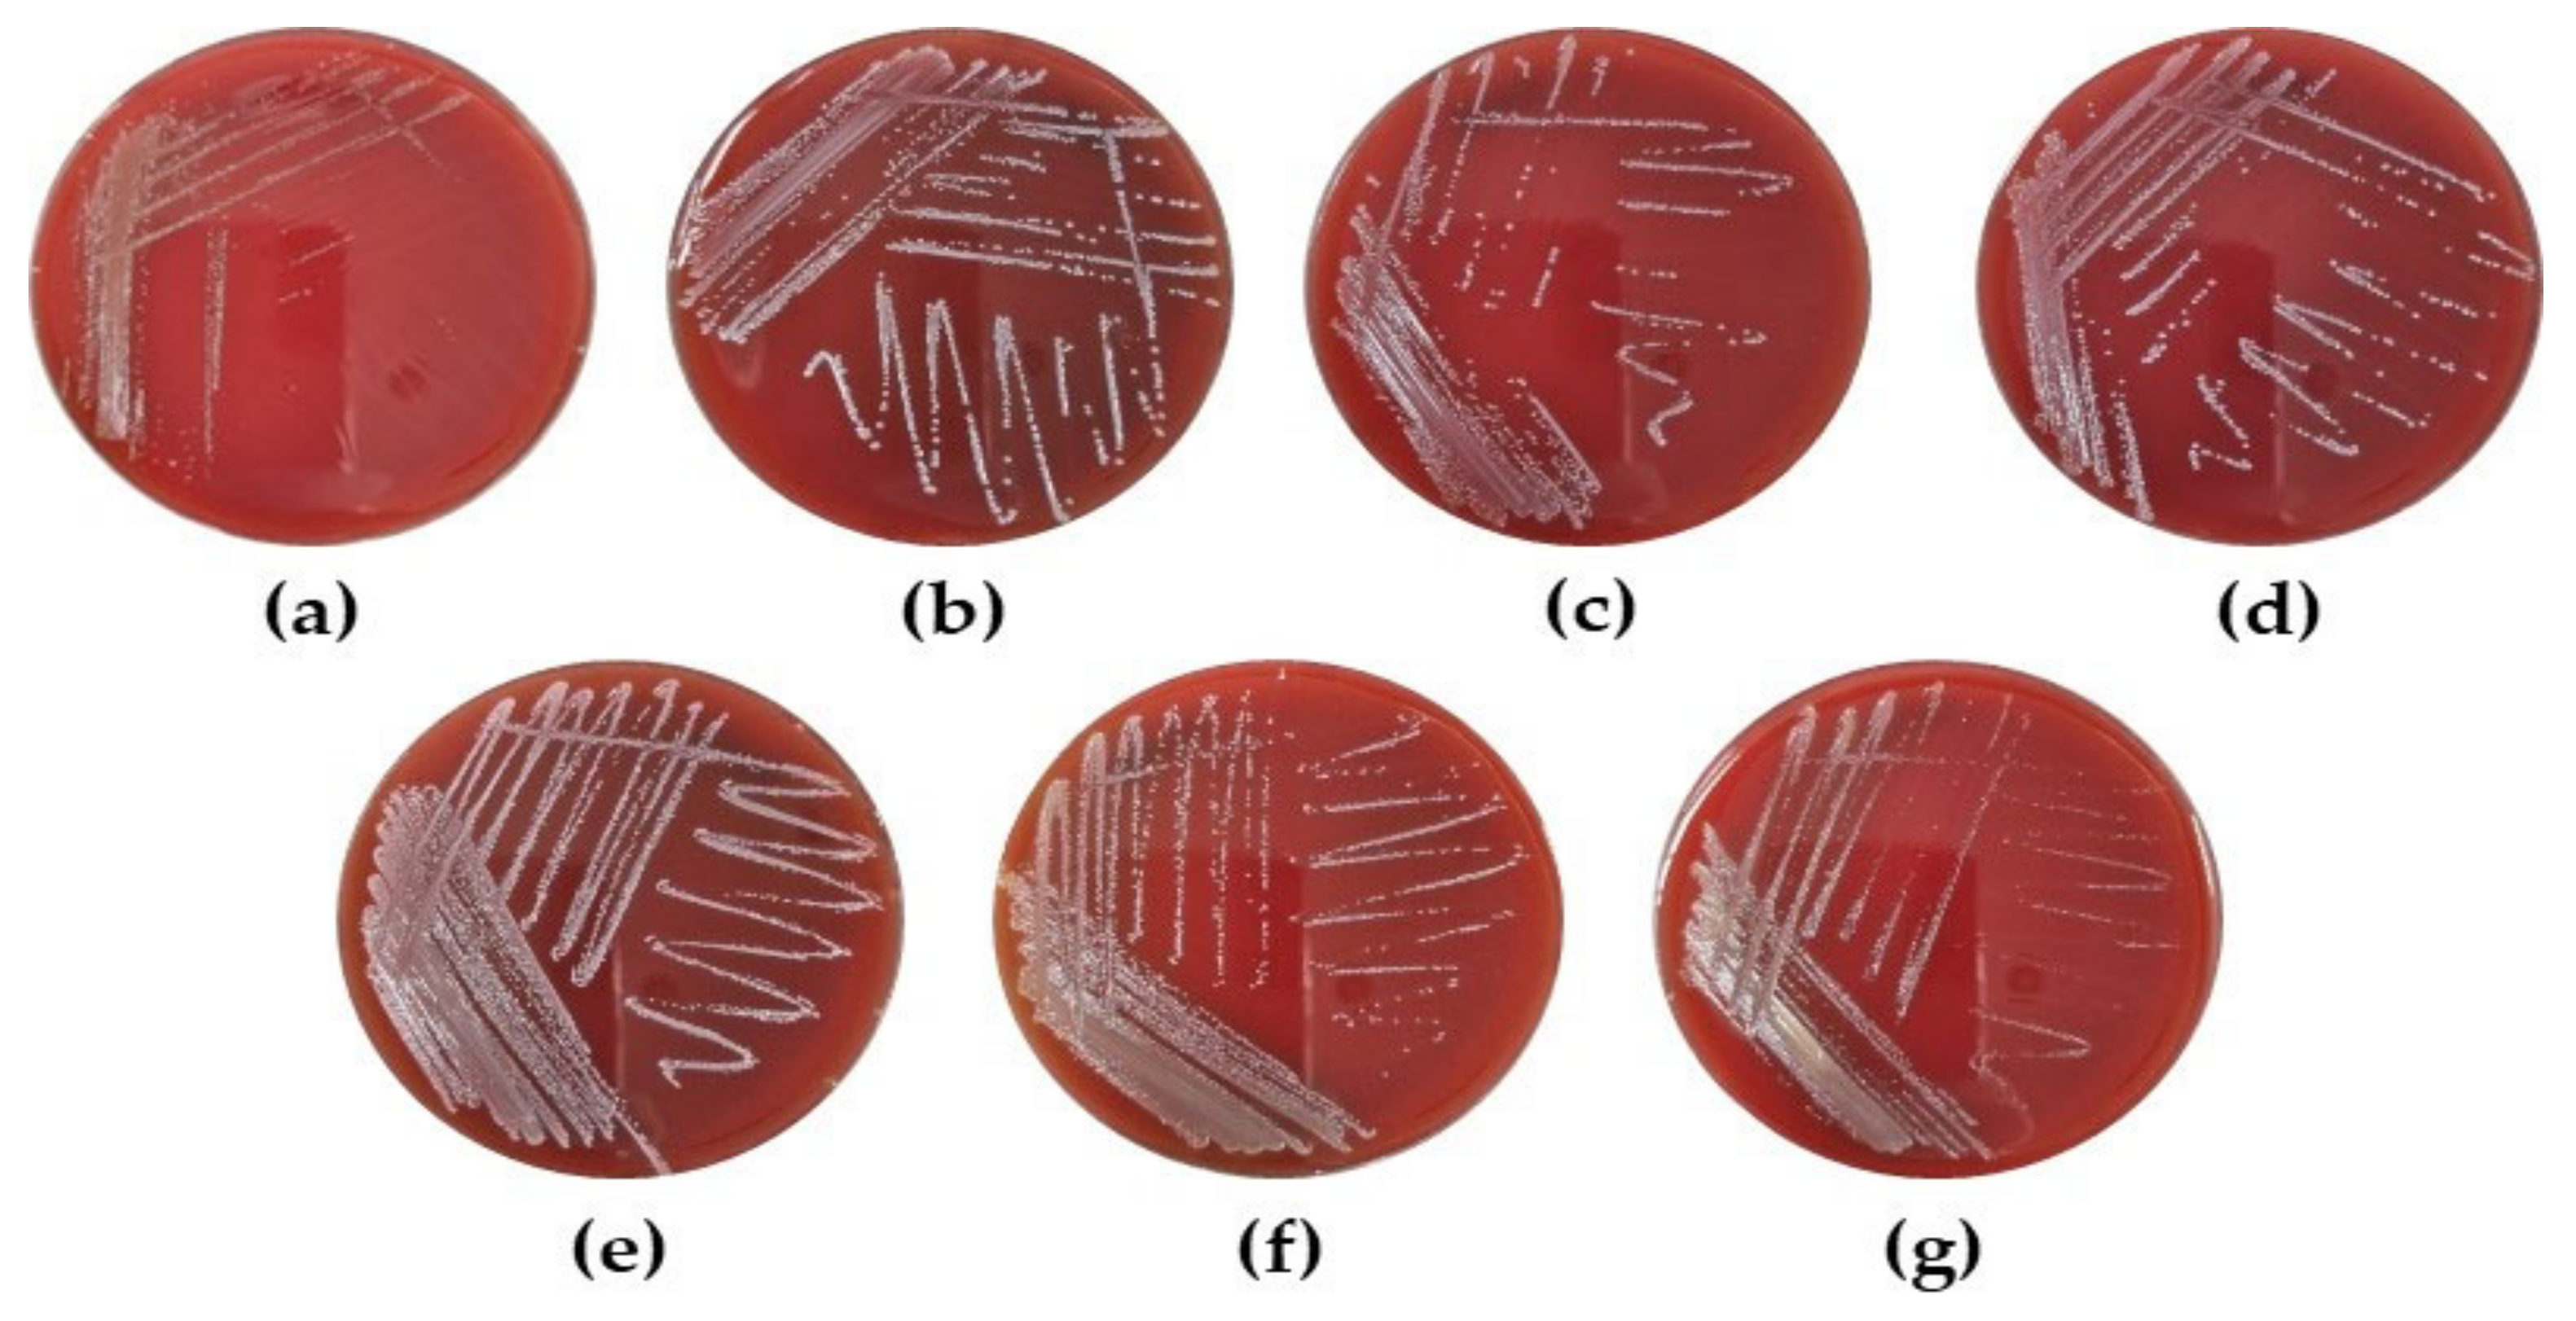
Microorganisms 10 02247 g006 Microorganisms 10 02247 g006

Immunostimulatory Activity of Lactic Acid Bacteria Cell-Free Supernatants through the Activation of NF-κB and MAPK Signaling Pathways in RAW 264.7 Cells
Abstract
1. Introduction
2. Materials and Methods
2.1. LAB Strains and Cultivation Conditions
2.2. Preparation of Cell-Free Supernatants (CFS)
2.3. Cell Culture
2.4. Cell Viability Assay
2.5. Determination of NO Production
2.6. Neutral Red Uptake Assay for Phagocytic Activity
2.7. Determination of Cytokines Production
2.8. Western Blot Analysis
2.9. Probiotic Properties
2.9.1. Resistance to Simulated Gastrointestinal Conditions
2.9.2. Hemolytic Activity
2.9.3. Antibiotic Susceptibility
2.10. Statistical Analysis
3. Results
3.1. The Effect of CFS from LAB Strains on Cell Viability and NO Production in RAW 264.7 Cells
3.2. Effect of CFS from LAB Strains on Phagocytic Activity in RAW 264.7 Cells
3.3. Effect of CFS from LAB Strains on iNOS/COX-2 Expression in RAW 264.7 Cells
3.4. Effect of CFS from LAB Strains on Cytokine Production in RAW 264.7 Cells
3.5. Effect of CFS from LAB Strains on NF-κB and MAPKs Activation in RAW 264.7 Cells
3.6. Probiotic Properties of the LAB Strains
3.6.1. Stability of LAB Strains under Simulated Gastrointestinal Conditions
3.6.2. Safety Evaluation of LAB Strains as Probiotics
4. Discussion
5. Conclusions
Author Contributions
Funding
Institutional Review Board Statement
Informed Consent Statement
Data Availability Statement
Acknowledgments
Conflicts of Interest
References
- Peters, V.B.M.; van de Steeg, E.; van Bilsen, J.; Meijerink, M. Mechanisms and immunomodulatory properties of pre- and probiotics. Benef. Microbes 2019, 10, 225–236. [Google Scholar] [CrossRef] [PubMed]
- Sattler, S. The Role of the Immune System Beyond the Fight Against Infection. Adv. Exp. Med. Biol. 2017, 1003, 3–14. [Google Scholar] [CrossRef] [PubMed]
- Hirayama, D.; Iida, T.; Nakase, H. The Phagocytic Function of Macrophage-Enforcing Innate Immunity and Tissue Homeostasis. Int. J. Mol. Sci. 2017, 19, 92. [Google Scholar] [CrossRef] [PubMed]
- Kang, C.H.; Kim, J.S.; Kim, H.; Park, H.M.; Paek, N.S. Heat-Killed Lactic Acid Bacteria Inhibit Nitric Oxide Production via Inducible Nitric Oxide Synthase and Cyclooxygenase-2 in RAW 264.7 Cells. Probiotics Antimicrob. Proteins 2021, 13, 1530–1538. [Google Scholar] [CrossRef]
- Geum, N.G.; Eo, H.J.; Kim, H.J.; Park, G.H.; Son, H.J.; Jeong, J.B. Immune-enhancing activity of Hydrangea macrophylla subsp. serrata leaves through TLR4/ROS-dependent activation of JNK and NF-κB in RAW264.7 cells and immunosuppressed mice. J. Funct. Foods 2020, 73, 104139. [Google Scholar] [CrossRef]
- Shreshtha, S.; Sharma, P.; Kumar, P.; Sharma, R.; Singh, S.P. Nitric oxide: It’s role in immunity. J. Clin. Diagn. Res. 2018, 12, BE01–BE05. [Google Scholar] [CrossRef]
- Miettinen, M.; Lehtonen, A.; Julkunen, I.; Matikainen, S. Lactobacilli and Streptococci activate NF-κB and STAT signaling pathways in human macrophages. J. Immunol. 2000, 164, 3733–3740. [Google Scholar] [CrossRef]
- Baeuerle, P.A.; Henkel, T. Function and activation of NF-kappa B in the immune system. Annu. Rev. Immunol. 1994, 12, 141–179. [Google Scholar] [CrossRef]
- Rao, K.M.K. MAP kinase activation in macrophages. J. Leukoc. Biol. 2001, 69, 3–10. [Google Scholar] [CrossRef]
- Valledor, A.F.; Sánchez-Tilló, E.; Arpa, L.; Park, J.M.; Caelles, C.; Lloberas, J.; Celada, A. Selective Roles of MAPKs during the Macrophage Response to IFN-γ. J. Immunol. 2008, 180, 4523–4529. [Google Scholar] [CrossRef]
- Kechagia, M.; Basoulis, D.; Konstantopoulou, S.; Dimitriadi, D.; Gyftopoulou, K.; Skarmoutsou, N.; Fakiri, E.M. Health Benefits of Probiotics: A Review. Int. Sch. Res. Not. 2013, 2013, 481651. [Google Scholar] [CrossRef] [PubMed]
- Das, T.K.; Pradhan, S.; Chakrabarti, S.; Mondal, K.C.; Ghosh, K. Current status of probiotic and related health benefits. Appl. Food Res. 2022, 2, 100185. [Google Scholar] [CrossRef]
- Zhu, J.; Zhao, L.; Guo, H.; Jiang, L.; Ren, F. Immunomodulatory effects of novel bifidobacterium and lactobacillus strains on murine macrophage cells. Adv. J. Microbiol. Res. 2018, 12, 8–15. [Google Scholar]
- Jin, S.W.; Lee, G.H.; Jang, M.J.; Hong, G.E.; Kim, J.Y.; Park, G.D.; Jin, H.; Kim, H.S.; Choi, J.H.; Choi, C.Y.; et al. Immunomodulatory Activity of Lactococcus lactis GCWB1176 in Cyclophosphamide-Induced Immunosuppression Model. Microorganisms 2020, 8, 1175. [Google Scholar] [CrossRef] [PubMed]
- Jung, J.-Y.; Shin, J.-S.; Lee, S.-G.; Rhee, Y.K.; Cho, C.-W.; Hong, H.-D.; Lee, K.-T. Lactobacillus sakei K040706 evokes immunostimulatory effects on macrophages through TLR 2-mediated activation. Int. Immunopharmacol. 2015, 28, 88–96. [Google Scholar] [CrossRef] [PubMed]
- Lee, J.Y.; Kang, J.H.; Jung, Y.R.; Kang, C.H. Lactobacillus gasseri MG4247 and Lacticaseibacillus paracasei MG4272 and MG4577 Modulate Allergic Inflammatory Response in RAW 264.7 and RBL-2H3 cells. Probiotics Antimicrob. Proteins 2022, 31, 1–10. [Google Scholar] [CrossRef] [PubMed]
- Chang, C.-K.; Wang, S.-C.; Chiu, C.-K.; Chen, S.-Y.; Chen, Z.-T.; Duh, P.-D. Der Effect of lactic acid bacteria isolated from fermented mustard on immunopotentiating activity. Asian Pac. J. Trop. Biomed. 2015, 5, 281–286. [Google Scholar] [CrossRef]
- Wei, J.; Wang, B.; Chen, Y.; Wang, Q.; Ahmed, A.F.; Zhang, Y.; Kang, W. The Immunomodulatory Effects of Active Ingredients From Nigella sativa in RAW264.7 Cells Through NF-κB/MAPK Signaling Pathways. Front. Nutr. 2022, 9, 1024. [Google Scholar] [CrossRef]
- Qi, X.; Simsek, S.; Chen, B.; Rao, J. Alginate-based double-network hydrogel improves the viability of encapsulated probiotics during simulated sequential gastrointestinal digestion: Effect of biopolymer type and concentrations. Int. J. Biol. Macromol. 2020, 165, 1675–1685. [Google Scholar] [CrossRef]
- Buxton, R. Blood Agar Plates and Hemolysis Protocols. Am. Soc. Microbiol. 2005, 30, 1–9. [Google Scholar]
- EFSA Panel on Additives and Products or Substances used in Animal Feed (FEEDAP); Rychen, G.; Aquilina, G.; Azimonti, G.; Bampidis, V.; de Lourdes Bastos, M.; Bories, G.; Chesson, A.; Cocconcelli, P.S.; Flachowsky, G.; et al. Guidance on the characterisation of microorganisms used as feed additives or as production organisms. EFSA J. 2018, 16, e05206. [Google Scholar] [CrossRef] [PubMed]
- Huang, D.; Yang, L.; Wang, C.; Ma, S.; Cui, L.; Huang, S.; Sheng, X.; Weng, Q.; Xu, M. Immunostimulatory Activity of Protein Hydrolysate from Oviductus Ranae on Macrophage In Vitro. Evid. Based. Complement. Alternat. Med. 2014, 2014, 180234. [Google Scholar] [CrossRef] [PubMed]
- Yan, F.; Polk, D.B. Probiotics and immune health. Curr. Opin. Gastroenterol. 2011, 27, 496–501. [Google Scholar] [CrossRef] [PubMed]
- Vanderpool, C.; Yan, F.; Polk, B.D. Mechanisms of probiotic action: Implications for therapeutic applications in inflammatory bowel diseases. Inflamm. Bowel Dis. 2008, 14, 1585–1596. [Google Scholar] [CrossRef]
- Yan, F.; Polk, D.B. Probiotics: Progress toward novel therapies for intestinal diseases. Curr. Opin. Gastroenterol. 2010, 26, 95–101. [Google Scholar] [CrossRef]
- Kwon, A.; Park, Y.S. Immunostimulatory activity of synbiotics using lactococcus lactis sg-030 and glucooligosaccharides from weissella cibaria yrk005. Microorganisms 2021, 9, 2437. [Google Scholar] [CrossRef]
- Park, H.-E.; Do, K.-H.; Lee, W.-K. The immune-modulating effects of viable Weissella cibaria JW15 on RAW 264. 7 macrophage cells. 2020, 34, 36–43. [Google Scholar] [CrossRef]
- Billack, B. Macrophage Activation: Role of Toll-like Receptors, Nitric Oxide, and Nuclear Factor kappa B. Am. J. Pharm. Educ. 2006, 70, 102. [Google Scholar] [CrossRef]
- Maghsood, F.; Mirshafiey, A.; Farahani, M.M.; Modarressi, M.H.; Jafari, P.; Motevaseli, E. Dual Effects of Cell Free Supernatants from Lactobacillus acidophilus and Lactobacillus rhamnosus GG in Regulation of MMP-9 by Up-Regulating TIMP-1 and Down-Regulating CD147 in PMADifferentiated THP-1 Cells. Cell J. 2018, 19, 559–568. [Google Scholar] [CrossRef]
- De Marco, S.; Sichetti, M.; Muradyan, D.; Piccioni, M.; Traina, G.; Pagiotti, R.; Pietrella, D. Probiotic cell-free supernatants exhibited anti-inflammatory and antioxidant activity on human gut epithelial cells and macrophages stimulated with LPS. Evid.-Based Complement. Altern. Med. 2018, 2018, 1756308. [Google Scholar] [CrossRef]
- Jeong, M.; Kim, J.H.; Lee, J.S.; Kang, S.D.; Shim, S.; Jung, M.Y.; Yang, H.; Byun, S.; Lee, K.W. Heat-Killed Lactobacillus brevis Enhances Phagocytic Activity and Generates Immune-Stimulatory Effects through Activating the TAK1 Pathway. J. Microbiol. Biotechnol. 2020, 30, 1395–1403. [Google Scholar] [CrossRef] [PubMed]
- Vincenti, J.E.; Wright, D.A.; Sarker, M. The influence of cell-free Lactobacillus rhamnosus GG supernatant on the phagocytic activity of macrophages. Biosci. Horizons Int. J. Student Res. 2010, 3, 105–112. [Google Scholar] [CrossRef][Green Version]
- Xiu, L.; Zhang, H.; Hu, Z.; Liang, Y.; Guo, S.; Yang, M.; Du, R.; Wang, X. Immunostimulatory activity of exopolysaccharides from probiotic lactobacillus casei WXD030 strain as a novel adjuvant in vitro and in vivo. Food Agric. Immunol. 2018, 29, 1086–1105. [Google Scholar] [CrossRef]
- Wang, Y.; Liu, H.; Zhao, J. Macrophage Polarization Induced by Probiotic Bacteria: A Concise Review. Probiotics Antimicrob. Proteins 2020, 12, 798–808. [Google Scholar] [CrossRef]
- Lee, H.W.; Choi, I.W.; Ha, S.K. Immunostimulatory Activities of Theobromine on Macrophages via the Activation of MAPK and NF-κB Signaling Pathways. Curr. Issues Mol. Biol. 2022, 44, 4216–4228. [Google Scholar] [CrossRef]
- Duque, G.A.; Descoteaux, A. Macrophage cytokines: Involvement in immunity and infectious diseases. Front. Immunol. 2014, 5, 491. [Google Scholar] [CrossRef]
- Ren, C.; Cheng, L.; Sun, Y.; Zhang, Q.; de Haan, B.J.; Zhang, H.; Faas, M.M.; de Vos, P. Lactic acid bacteria secrete toll like receptor 2 stimulating and macrophage immunomodulating bioactive factors. J. Funct. Foods 2020, 66, 103783. [Google Scholar] [CrossRef]
- Liu, T.; Zhang, L.; Joo, D.; Sun, S.C. NF-κB signaling in inflammation. Signal Transduct. Target. Ther. 2017, 2, 17023. [Google Scholar] [CrossRef]
- Giridharan, S.; Srinivasan, M. Mechanisms of NF-κB p65 and strategies for therapeutic manipulation. J. Inflamm. Res. 2018, 11, 407–419. [Google Scholar] [CrossRef]
- Jang, H.J.; Yu, H.S.; Lee, N.K.; Paik, H.D. Immune-stimulating Effect of Lactobacillus plantarum Ln1 Isolated from the Traditional Korean Fermented Food, Kimchi. J. Microbiol. Biotechnol. 2020, 30, 926–929. [Google Scholar] [CrossRef]
- Jang, S.E.; Joh, E.H.; Lee, H.Y.; Ahn, Y.T.; Lee, J.H.; Huh, C.S.; Han, M.J.; Kim, D.H. Lactobacillus plantarum HY7712 ameliorates cyclophosphamide-induced immunosuppression in mice. J. Microbiol. Biotechnol. 2013, 23, 414–421. [Google Scholar] [CrossRef] [PubMed]
- Neamatallah, T. Mitogen-Activated Protein Kinase Pathway: A Critical Regulator in Tumor-associated Macrophage Polarization. J. Microsc. Ultrastruct. 2019, 7, 53–55. [Google Scholar] [CrossRef] [PubMed]
- Olson, C.M.; Hedrick, M.N.; Izadi, H.; Bates, T.C.; Olivera, E.R.; Anguita, J. p38 mitogen-activated protein kinase controls NF-κB transcriptional activation and tumor necrosis factor alpha production through RelA phosphorylation mediated by mitogen- and stress-activated protein kinase 1 in response to Borrelia burgdorferi antigens. Infect. Immun. 2007, 75, 270–277. [Google Scholar] [CrossRef]
- Lee, S.; Song, I.H.; Park, Y.S. In Vivo and In Vitro Study of Immunostimulation by Leuconostoc lactis-Produced Gluco-Oligosaccharides. Molecules 2019, 24, 3994. [Google Scholar] [CrossRef] [PubMed]
- Sim, J.-H.; Oh, S.-J.; Kim, S.-K.; Baek, Y.-J. Comparative Tests on the Acid Tolerance of Some Lactic-Acid-Bacteria Species Isolated from Lactic Fermented Products. Korean J. Food Sci. Technol. 1995, 27, 101–104. [Google Scholar]
- Silva, C.C.G.; Domingos-Lopes, M.F.P.; Magalhães, V.A.F.; Freitas, D.A.S.R.; Coelho, M.C.; Rosa, H.J.D.; Dapkevicius, M.L.N.E. Latin-style fresh cheese enhances lactic acid bacteria survival but not Listeria monocytogenes resistance under in vitro simulated gastrointestinal conditions. J. Dairy Sci. 2015, 98, 4377–4383. [Google Scholar] [CrossRef]
- Naissinger da Silva, M.; Tagliapietra, B.L.; Flores, V.d.A.; Pereira dos Santos Richards, N.S. In vitro test to evaluate survival in the gastrointestinal tract of commercial probiotics. Curr. Res. Food Sci. 2021, 4, 320–325. [Google Scholar] [CrossRef]
- Stasiak-Różańska, L.; Berthold-Pluta, A.; Pluta, A.S.; Dasiewicz, K.; Garbowska, M. Effect of Simulated Gastrointestinal Tract Conditions on Survivability of Probiotic Bacteria Present in Commercial Preparations. Int. J. Environ. Res. Public Health 2021, 18, 1108. [Google Scholar] [CrossRef]
- Bengoa, A.A.; Zavala, L.; Carasi, P.; Trejo, S.A.; Bronsoms, S.; Serradell, M.d.l.Á.; Garrote, G.L.; Abraham, A.G. Simulated gastrointestinal conditions increase adhesion ability of Lactobacillus paracasei strains isolated from kefir to Caco-2 cells and mucin. Food Res. Int. 2018, 103, 462–467. [Google Scholar] [CrossRef]
- De Lacerda, J.R.M.; da Silva, T.F.; Vollú, R.E.; Marques, J.M.; Seldin, L. Generally recognized as safe (GRAS) Lactococcus lactis strains associated with Lippia sidoides Cham. are able to solubilize/mineralize phosphate. Springerplus 2016, 5, 828. [Google Scholar] [CrossRef]
- Jo, Y.M.; Kim, G.Y.; Kim, S.A.; Cheon, S.W.; Kang, C.H.; Han, N.S. Limosilactobacillus fermentum MG7011: An Amylase and Phytase Producing Starter for the Preparation of Rice-Based Probiotic Beverages. Front. Microbiol. 2021, 12, 2895. [Google Scholar] [CrossRef] [PubMed]
- Buddhasiri, S.; Sukjoi, C.; Kaewsakhorn, T.; Nambunmee, K.; Nakphaichit, M.; Nitisinprasert, S.; Thiennimitr, P. Anti-inflammatory Effect of Probiotic Limosilactobacillus reuteri KUB-AC5 Against Salmonella Infection in a Mouse Colitis Model. Front. Microbiol. 2021, 12, 716761. [Google Scholar] [CrossRef] [PubMed]
- Georgieva, R.; Yocheva, L.; Tserovska, L.; Zhelezova, G.; Stefanova, N.; Atanasova, A.; Danguleva, A.; Ivanova, G.; Karapetkov, N.; Rumyan, N.; et al. Antimicrobial activity and antibiotic susceptibility of Lactobacillus and Bifidobacterium spp. intended for use as starter and probiotic cultures. Biotechnol. Biotechnol. Equip. 2015, 29, 84–91. [Google Scholar] [CrossRef] [PubMed]
- Pavli, F.G.; Argyri, A.; Papadopoulou, O.S. Probiotic Potential of Lactic Acid Bacteria from Traditional Fermented Dairy and Meat Products: Assessment by In Vitro Tests and Molecular Characterization. J. Probiotics Heal. 2016, 4, 157. [Google Scholar] [CrossRef]
- Gueimonde, M.; Sánchez, B.; de los Reyes-Gavilán, C.G.; Margolles, A. Antibiotic resistance in probiotic bacteria. Front. Microbiol. 2013, 4, 202. [Google Scholar] [CrossRef] [PubMed]

| Origin | Strains | Cell Viability (%) | NO (μM) |
|---|---|---|---|
| Untreated | 100.00 ± 0.48 a | 1.00 ± 0.06 h | |
| LPS (10 ng/mL) | 99.69 ± 2.92 a | 19.27 ± 2.80 c | |
| Food | Lacticaseibacillus rhamnosus MG5007 | 101.84 ± 3.40 a | 4.11 ± 0.40 g |
| Lactococcuslactis MG5399 | 98.92 ± 5.21 a | 2.84 ± 0.29 g | |
| Lactococcuslactis MG5403 | 100.56 ± 0.77 a | 4.09 ± 1.09 g | |
| Limosilactobacillus reuteri MG5462 | 101.25 ± 1.96 a | 21.73 ± 0.95 b | |
| Lactococcuslactis MG5479 | 103.88 ± 1.47 a | 6.94 ± 0.52 f | |
| Lactococcuslactis MG5508 | 100.49 ± 2.17 a | 3.23 ± 0.44 g | |
| Fermented food | Lacticaseibacillus paracasei MG5179 | 100.88 ± 4.82 a | 4.81 ± 0.21 g |
| Lactococcuslactis MG5126 | 101.08 ± 1.74 a | 4.28 ± 1.04 g | |
| Lactococcuslactis MG5278 | 100.62 ± 0.98 a | 10.60 ± 0.72 e | |
| Lactococcuslactis MG5452 | 100.95 ± 1.04 a | 3.13 ± 0.76 g | |
| Lactococcuslactis MG5474 | 101.40 ± 0.76 a | 14.13 ± 0.90 d | |
| Lactococcuslactis MG5542 | 100.05 ± 2.67 a | 3.99 ± 1.32 g | |
| Human | Limosilactobacillus fermentum MG4263 | 100.65 ± 2.48 a | 21.47 ± 1.14 b |
| Limosilactobacillus fermentum MG4268 | 101.29 ± 3.44 a | 20.87 ± 2.02 bc | |
| Limosilactobacillus fermentum MG4282 | 101.26 ± 1.77 a | 25.73 ± 0.12 a | |
| Bifidobacterium lactis MG4568 | 100.05 ± 2.67 a | 4.69 ± 0.10 g | |
| Bifidobacterium lactis MG4569 | 102.83 ± 1.08 a | 4.73 ± 0.16 g | |
| Lactococcuslactis MG4668 | 101.51 ± 1.65 a | 8.04 ± 1.55 f | |
| Limosilactobacillus reuteri MG4722 | 101.58 ± 2.02 a | 4.17 ± 0.03 g | |
| Limosilactobacillus reuteri MG5149 | 100.09 ± 3.12 a | 4.58 ± 0.27 g |
| Strains | Initial Counts (log CFU/mL) | SGF (log CFU/mL) | SIF (log CFU/mL) | Survival Rate (%) |
|---|---|---|---|---|
| L. reuteri MG5462 | 7.70 ± 0.01 | 7.66 ± 0.00 | 7.50 ± 0.00 | 97.41 ± 0.02 |
| Lc. lactis MG4668 | 7.59 ± 0.06 | 2.85 ± 0.00 | 2.75 ± 0.10 | 36.27 ± 1.27 |
| Lc. lactis MG5278 | 7.29 ± 0.06 | 2.74 ± 0.04 | 2.61 ± 0.01 | 35.78 ± 0.07 |
| Lc. lactis MG5474 | 7.66 ± 0.02 | 2.78 ± 0.07 | 2.39 ± 0.36 | 31.24 ± 4.66 |
| L. fermentum MG4263 | 7.87 ± 0.01 | 3.27 ± 0.01 | 3.09 ± 0.01 | 39.25 ± 0.09 |
| L. fermentum MG4268 | 7.89 ± 0.02 | 4.11 ± 0.05 | 3.74 ± 0.15 | 47.40 ± 1.84 |
| L. fermentum MG4282 | 7.92 ± 0.01 | 3.96 ± 0.03 | 3.92 ± 0.08 | 49.58 ± 0.98 |
| Antibiotics | Susceptibility (S/R) | ||||||
|---|---|---|---|---|---|---|---|
| MG5462 | MG4668 | MG5278 | MG5474 | MG4263 | MG4268 | MG4282 | |
| Ampicillin | S | S | S | S | S | S | S |
| Gentamicin | S | S | S | S | S | S | S |
| Kanamycin | S | S | S | S | S | S | S |
| Streptomycin | S | S | S | S | S | S | S |
| Tetracycline | S | S | S | S | S | S | S |
| Chloramphenicol | R | S | S | S | R | S | S |
| Erythromycin | S | S | S | S | S | S | S |
| Vancomycin | n.r | S | S | S | n.r | n.r | n.r |
| Clindamycin | S | S | S | S | S | S | S |
Publisher’s Note: MDPI stays neutral with regard to jurisdictional claims in published maps and institutional affiliations. |
© 2022 by the authors. Licensee MDPI, Basel, Switzerland. This article is an open access article distributed under the terms and conditions of the Creative Commons Attribution (CC BY) license (https://creativecommons.org/licenses/by/4.0/).
Share and Cite
Lee, J.; Kim, S.; Kang, C.-H. Immunostimulatory Activity of Lactic Acid Bacteria Cell-Free Supernatants through the Activation of NF-κB and MAPK Signaling Pathways in RAW 264.7 Cells. Microorganisms 2022, 10, 2247. https://doi.org/10.3390/microorganisms10112247
Lee J, Kim S, Kang C-H. Immunostimulatory Activity of Lactic Acid Bacteria Cell-Free Supernatants through the Activation of NF-κB and MAPK Signaling Pathways in RAW 264.7 Cells. Microorganisms. 2022; 10(11):2247. https://doi.org/10.3390/microorganisms10112247
Chicago/Turabian StyleLee, Jaekoo, Seonyoung Kim, and Chang-Ho Kang. 2022. "Immunostimulatory Activity of Lactic Acid Bacteria Cell-Free Supernatants through the Activation of NF-κB and MAPK Signaling Pathways in RAW 264.7 Cells" Microorganisms 10, no. 11: 2247. https://doi.org/10.3390/microorganisms10112247
APA StyleLee, J., Kim, S., & Kang, C.-H. (2022). Immunostimulatory Activity of Lactic Acid Bacteria Cell-Free Supernatants through the Activation of NF-κB and MAPK Signaling Pathways in RAW 264.7 Cells. Microorganisms, 10(11), 2247. https://doi.org/10.3390/microorganisms10112247

